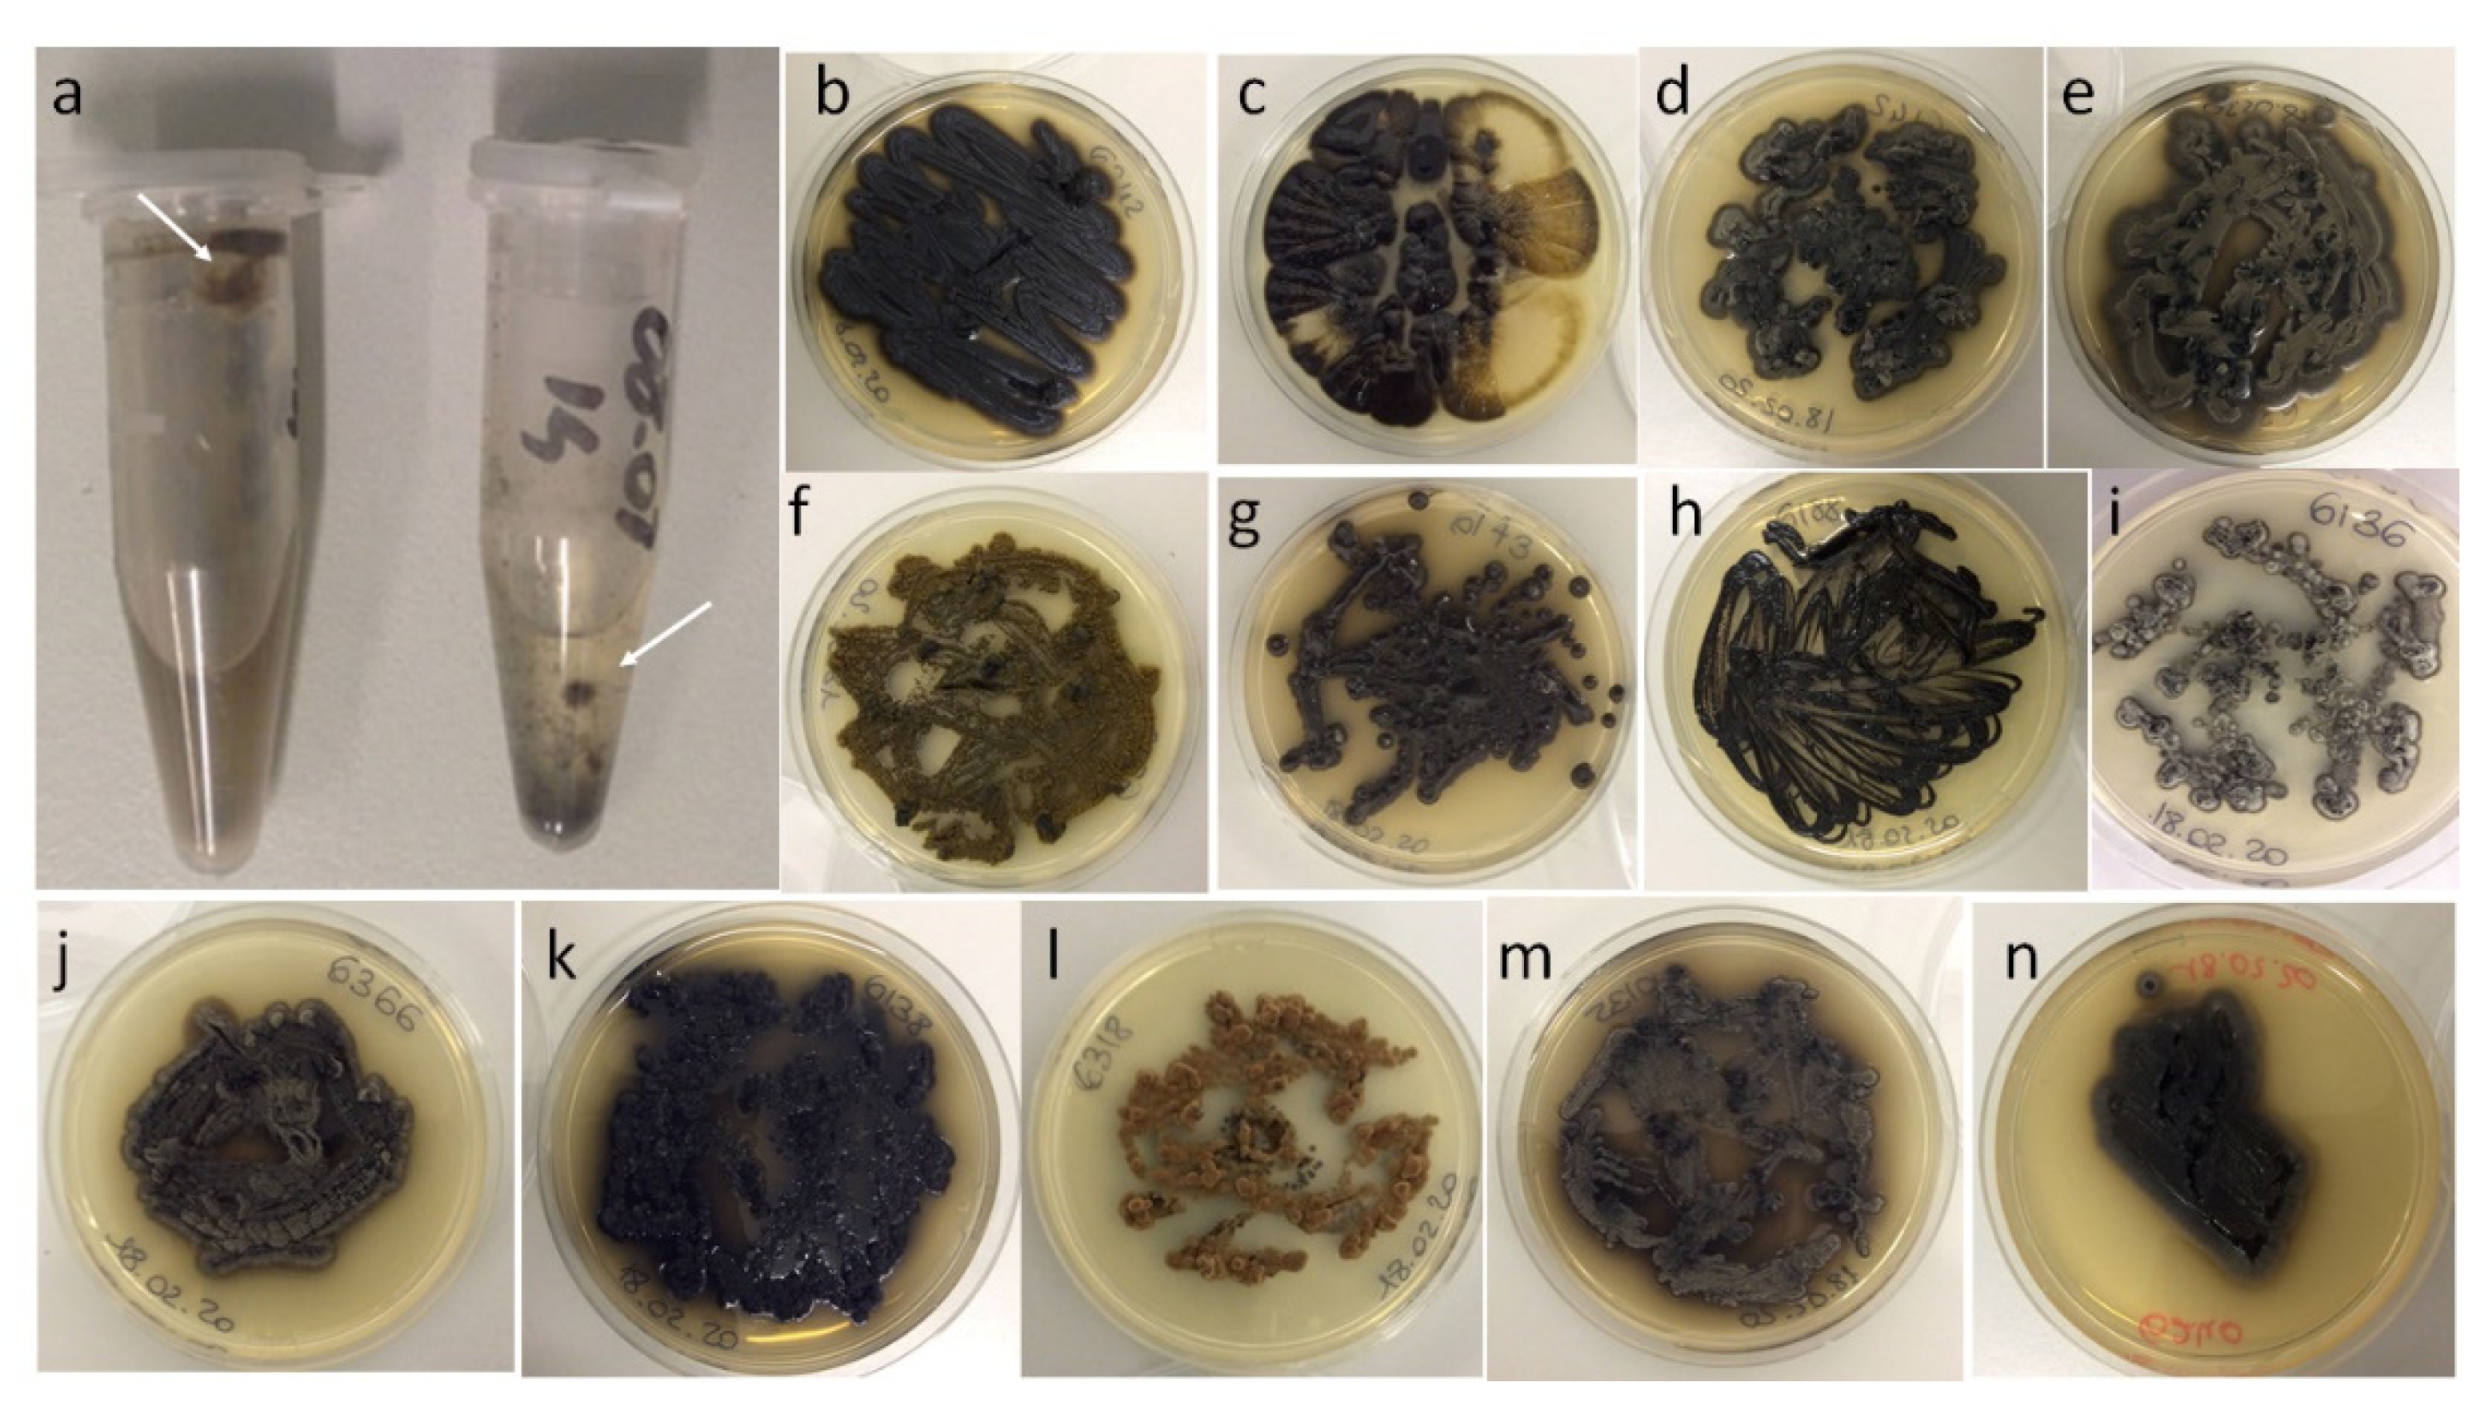
Jof 07 00817 g002 Jof 07 00817 g002

Hydrocarbon-Contaminated Sites: Is There Something More Than Exophiala xenobiotica? New Insights into Black Fungal Diversity Using the Long Cold Incubation Method
Abstract
1. Introduction
2. Materials and Methods
2.1. Sampling
2.2. Isolation Protocols
2.3. Molecular Identification
2.4. Black Fungal Diversity
2.5. Statistical Analysis
3. Results
3.1. General Isolation and Molecular Identification Results
3.2. Black Fungal Diversity
3.2.1. Black Fungal Diversity in the Three Fuel-Contaminated Sites
3.2.2. Black Fungal Diversity with Regard to the Isolation Methods
3.2.3. Diversity of New Fungal Taxa
4. Discussion
5. Conclusions
Supplementary Materials
Author Contributions
Funding
Institutional Review Board Statement
Informed Consent Statement
Data Availability Statement
Acknowledgments
Conflicts of Interest
References
- Grube, M.; Muggia, L.; Gostinčar, C. Niches and adaptations of polyextremotolerant black fungi. In Polyextremophiles; Seckbach, J., Oren, A., Stan-Lotter, H., Eds.; Springer: Dordrecht, The Netherlands, 2013; pp. 551–566. [Google Scholar]
- Selbmann, L.; Isola, D.; Egidi, E.; Zucconi, L.; Gueidan, C.; de Hoog, G.S.; Onofri, S. Mountain tips as reservoirs for new rock-fungal entities: Saxomyces gen. nov. and four new species from the Alps. Fungal Divers. 2014, 65, 167–182. [Google Scholar] [CrossRef]
- Sterflinger, K. Black yeasts and meristematic fungi: Ecology, diversity and identification. In The Yeast Handbook; Seckbach, J., Ed.; Biodiversity and Ecophysiology of Yeasts; Springer: Berlin, Germany, 2005; pp. 501–514. [Google Scholar]
- Gandra, S.; Ram, M.S.; Levitz, S.M. The “Black Fungus” in India: The emerging syndemic of COVID-19–Associated Mucormycosis. Ann. Intern. Med. 2021, 174, 1301–1302. [Google Scholar] [CrossRef] [PubMed]
- Selbmann, L.; de Hoog, G.S.; Zucconi, L.; Isola, D.; Onofri, S. Black yeasts in cold habitats. In Cold-adapted Yeasts; Buzzini, P., Margesin, R., Eds.; Springer: Berlin/Heidelberg, Germany, 2014; pp. 173–189. [Google Scholar] [CrossRef]
- Prenafeta-Boldú, F.X.; Armjio-Medina, C.; Isola, D. Black fungi in the built environment–the good, the bad, and the ugly. In Viruses, Bacteria, and Fungi in the Built Environment. Designing Healthy Indoor Environments; Pacheco-Torgal, F., Ivanov, V., Falkinham, J.O., Eds.; Elsevier- Woodhead Publishing Science &Technology books: Duxford, UK, 2021; in press. [Google Scholar]
- de Hoog, G.; Vicente, V.; Najafzadeh, M.J.; Harrak, M.; Badali, H.; Seyedmousavi, S. Waterborne Exophiala species causing disease in cold-blooded animals. Persoonia—Mol. Phylogeny Evol. Fungi 2011, 27, 46–72. [Google Scholar] [CrossRef] [PubMed]
- Prenafeta-Boldú, F.X.; Summerbell, R.; de Hoog, G.S. Fungi growing on aromatic hydrocarbons: Biotechnology’s unexpected encounter with biohazard? FEMS Microbiol. Rev. 2006, 30, 109–130. [Google Scholar] [CrossRef]
- Sav, H.; Ozakkas, F.; Altınbas, R.; Kiraz, N.; Tümgör, A.; Gümral, R.; Döğen, A.; Ilkit, M.; de Hoog, G.S. Virulence markers of opportunistic black yeast in Exophiala. Mycoses 2016, 59, 343–350. [Google Scholar] [CrossRef]
- Prenafeta-Boldú, F.X.; de Hoog, G.S.; Summerbell, R.C. Fungal communities in hydrocarbon degradation. In Microbial Communities Utilizing Hydrocarbons and Lipids: Members, Metagenomics and Ecophysiology; McGenity, T.J., Ed.; Springer: Cham, Switzerland, 2018; pp. 1–36. [Google Scholar] [CrossRef]
- Babič, M.N.; Zupančič, J.; Gunde-Cimerman, N.; de Hoog, S.; Zalar, P. Ecology of the human opportunistic black yeast Exophiala dermatitidis indicates preference for human-made habitats. Mycopathol. 2018, 183, 201–212. [Google Scholar] [CrossRef]
- Babič, M.N.; Zalar, P.; Ženko, B.; Džeroski, S.; Gunde-Cimerman, N. Yeasts and yeast-like fungi in tap water and groundwater, and their transmission to household appliances. Fungal Ecol. 2016, 20, 30–39. [Google Scholar] [CrossRef]
- Döğen, A.; Kaplan, E.; Öksüz, Z.; Serin, M.S.; Ilkit, M.; de Hoog, G.S. Dishwashers are a major source of human opportunistic yeast-like fungi in indoor environments in Mersin, Turkey. Med. Mycol. 2013, 51, 493–498. [Google Scholar] [CrossRef]
- Raghupathi, P.K.; Zupančič, J.; Brejnrod, A.D.; Jacquiod, S.; Houf, K.; Burmølle, M.; Gunde-Cimerman, N.; Sørensen, S.J. Microbial diversity and putative opportunistic pathogens in dishwasher biofilm communities. Appl. Environ. Microbiol. 2018, 84, 84. [Google Scholar] [CrossRef]
- Zalar, P.; Novak, M.; de Hoog, G.S.; Gunde-Cimerman, N. Dishwashers—A man-made ecological niche accommodating human opportunistic fungal pathogens. Fungal Biol. 2011, 115, 997–1007. [Google Scholar] [CrossRef]
- Zupančič, J.; Babič, M.N.; Zalar, P.; Gunde-Cimerman, N. The black yeast Exophiala dermatitidis and other selected opportunistic human fungal pathogens spread from dishwashers to kitchens. PLoS ONE 2016, 11, e0148166. [Google Scholar] [CrossRef]
- Hamada, N.; Abe, N. Physiological characteristics of 13 common fungal species in bathrooms. Mycoscience 2009, 50, 421–429. [Google Scholar] [CrossRef]
- Hamada, N.; Abe, N. Growth characteristics of four fungal species in bathrooms. Biocontrol Sci. 2010, 15, 111–115. [Google Scholar] [CrossRef] [PubMed]
- Lian, X.; de Hoog, G.S. Indoor wet cells harbour melanized agents of cutaneous infection. Med. Mycol. 2010, 48, 622–628. [Google Scholar] [CrossRef] [PubMed]
- Samerpitak, K.; Gloyna, K.; Gerrits van den Ende, A.H.G.; de Hoog, G.S. A novel species of the oligotrophic genus Ochroconis colonizing indoor wet cells. Mycoscience 2017, 58, 290–296. [Google Scholar] [CrossRef]
- Wang, X.; Cai, W.; Gerrits van den Ende, A.H.G.; Zhang, J.; Xie, T.; Xi, L.; Li, X.; Sun, J.; de Hoog, G.S. Indoor wet cells as a habitat for melanized fungi, opportunistic pathogens on humans and other vertebrates. Sci. Rep. 2018, 8, 1–10. [Google Scholar] [CrossRef]
- Hamada, N. Growth on various detergent components of fungi found in washing machines. Seikatsu Eisei 2005, 49, 161–167. [Google Scholar] [CrossRef]
- Hamada, N. Characteristics of fungi growing inside washing machines. Seikatsu Eisei 2005, 49, 108–113. [Google Scholar] [CrossRef]
- Isola, D.; Selbmann, L.; de Hoog, G.S.; Fenice, M.; Onofri, S.; Prenafeta-Boldú, F.X.; Zucconi, L. Isolation and screening of black fungi as degraders of volatile aromatic hydrocarbons. Mycopathologia 2013, 175, 369–379. [Google Scholar] [CrossRef]
- Nucci, M.; Akiti, T.; Barreiros, G.; Silveira, F.; Revankar, S.G.; Wickes, B.; Sutton, D.A.; Patterson, T.F. Nosocomial outbreak of Exophiala jeanselmei fungemia associated with contamination of hospital water. Clin. Infect. Dis. 2002, 34, 1475–1480. [Google Scholar] [CrossRef]
- Nishimura, K.; Miyaji, M.; Taguchi, H.; Tanaka, R. Fungi in bathwater and sludge of bathroom drainpipes. Mycopathologia 1987, 97, 17–23. [Google Scholar] [CrossRef] [PubMed]
- Matos, T.; de Hoog, G.S.; de Boer, A.G.; de Crom, I.; Haase, G.M. High prevalence of the neurotrope Exophiala dermatitidis and related oligotrophic black yeasts in sauna facilities. Mycoses 2002, 45, 373–377. [Google Scholar] [CrossRef] [PubMed]
- Döğen, A.; Ilkit, M.; de Hoog, G.S. Black yeast habitat choices and species spectrum on high altitude creosote-treated railway ties. Fungal Biol. 2013, 117, 692–696. [Google Scholar] [CrossRef] [PubMed]
- Döğen, A.; Kaplan, E.; Ilkit, M.; de Hoog, G.S. Massive contamination of Exophiala dermatitidis and E. phaeomuriformis in railway stations in subtropical Turkey. Mycopathologia 2012, 175, 381–386. [Google Scholar] [CrossRef] [PubMed]
- Satow, M.; Attili-Angelis, D.; de Hoog, G.; Vicente, V. Selective factors involved in oil flotation isolation of black yeasts from the environment. Stud. Mycol. 2008, 61, 157–163. [Google Scholar] [CrossRef] [PubMed]
- Vicente, V.; Attili-Angelis, D.; Pie, M.; Queiroz-Telles, F.; Cruz, L.; Najafzadeh, M.J.; de Hoog, G.; Zhao, J.; Pizzirani-Kleiner, A. Environmental isolation of black yeast-like fungi involved in human infection. Stud. Mycol. 2008, 61, 137–144. [Google Scholar] [CrossRef]
- Baron, N.; Pagnocca, F.; Otsuka, A.; Prenafeta-Boldú, F.; Vicente, V.; de Angelis, D.A. Black Fungi and Hydrocarbons: An Environmental Survey for Alkylbenzene Assimilation. Microorganisms 2021, 9, 1008. [Google Scholar] [CrossRef] [PubMed]
- Sudhadham, M.; Prakitsin, S.; Sivichai, S.; Chaiyarat, R.; Dorrestein, G.; Menken, S.; de Hoog, G.S. The neurotropic black yeast Exophiala dermatitidis has a possible origin in the tropical rain forest. Stud. Mycol. 2008, 61, 145–155. [Google Scholar] [CrossRef]
- Prenafeta-Boldú, F.X.; Kuhn, A.; Luykx, D.M.A.M.; Heidrun, A.; van Groenestijn, J.W.; de Bont, J.A.M. Isolation and characterisation of fungi growing on volatile aromatic hydrocarbons as their sole carbon and energy source. Mycol. Res. 2001, 105, 477–484. [Google Scholar] [CrossRef]
- Quan, Y.; Gerrits van den Ende, A.H.G.; Shi, D.; Prenafeta-Boldú, F.X.; Liu, Z.; Al-Hatmi, A.M.S.; Ahmed, S.A.; Verweij, P.; Kang, Y.; de Hoog, G.S. A Comparison of isolation methods for black fungi degrading aromatic toxins. Mycopathologia 2019, 184, 653–660. [Google Scholar] [CrossRef]
- Zhao, J.; Zeng, J.; de Hoog, G.S.; Attili-Angelis, D.; Prenafeta-Boldú, F.X. Isolation and identification of black yeasts by enrichment on atmospheres of monoaromatic hydrocarbons. Microb. Ecol. 2010, 60, 149–156. [Google Scholar] [CrossRef] [PubMed]
- de Hoog, G.S.; Zeng, J.S.; Harrak, M.J.; Sutton, D.A. Exophiala xenobiotica sp. nov., an opportunistic black yeast inhabiting environments rich in hydrocarbons. Antonie van Leeuwenhoek 2006, 90, 257–268. [Google Scholar] [CrossRef] [PubMed]
- Isola, D.; Selbmann, L.; Egidi, E.; Onofri, S.; Zucconi, L. Black fungi from contaminated sites: One year later. In Proceedings of the fifth meeting of the ISHAM working groups on black yeasts and chromoblastomycosis, Guanzhou, China, 29 November–1 December 2013. [Google Scholar]
- Isola, D.; Zucconi, L.; Cecchini, A.; Caneva, G. Dark-pigmented biodeteriogenic fungi in Etruscan hypogeal tombs: New data on their culture-dependent diversity, favouring conditions, and resistance to biocidal treatments. Fungal Biol. 2021, 125, 609–620. [Google Scholar] [CrossRef]
- Tamura, K.; Stecher, G.; Peterson, D.; Filipski, A.; Kumar, S. MEGA6: Molecular Evolutionary Genetics Analysis Version 6.0. Mol. Biol. Evol. 2013, 30, 2725–2729. [Google Scholar] [CrossRef] [PubMed]
- Felsenstein, J. Confidence limits on phylogenies: An approach using the bootstrap. Evolution 1985, 39, 783–791. [Google Scholar] [CrossRef]
- Agresti, A.; Coull, B.A. Approximate is better than "exact" for interval estimation of binomial proportions. Am. Stat. 1998, 52, 119. [Google Scholar] [CrossRef]
- Hammer, Ø.; Harper, D.A.; Ryan, P.D. Past: Paleontological statistics software package for education and data analysis. Palaeontol. Electron 2001, 4, 9. [Google Scholar]
- Cheeptham, N. Advances and challenges in studying cave microbial diversity. In Cave Microbiomes: A Novel Resource for Drug Discovery; Cheeptham, N., Ed.; Springer Briefs in Microbiology; Springer: New York, NY, USA, 2013; Volume 1, pp. 1–34. ISBN 978-1-4614-5205-8. [Google Scholar]
- Molina-Menor, E.; Gimeno-Valero, H.; Pascual, J.; Peretó, J.; Porcar, M. High culturable bacterial diversity from a European desert: The Tabernas desert. Front. Microbiol. 2021, 11, 583120. [Google Scholar] [CrossRef]
- Martiny, A.C. High proportions of bacteria are culturable across major biomes. ISME J. 2019, 13, 2125–2128. [Google Scholar] [CrossRef]
- Martiny, A.C. The ‘1% culturability paradigm’ needs to be carefully defined. ISME J. 2020, 14, 10–11. [Google Scholar] [CrossRef]
- Magnuson, J.K.; Lasure, L.L. Fungal diversity in soils as assessed by direct culture and molecular techniques. In Proceedings of the 102nd General Meeting of the American Society for Microbiology, Salt Lake City, UT, USA, 19–23 May 2002; pp. 19–23. [Google Scholar]
- Gams, W. Biodiversity of soil-inhabiting fungi. Biodivers. Conserv. 2006, 16, 69–72. [Google Scholar] [CrossRef]
- Hawksworth, D.L. The fungal dimension of biodiversity: Magnitude, significance, and conservation. Mycol. Res. 1991, 95, 641–655. [Google Scholar] [CrossRef]
- Hawksworth, D.L. The magnitude of fungal diversity: The 1.5 million species estimate revisited. Mycol. Res. 2001, 105, 1422–1432. [Google Scholar] [CrossRef]
- Blackwell, M. The Fungi: 1, 2, 3 … 5.1 million species? Am. J. Bot. 2011, 98, 426–438. [Google Scholar] [CrossRef]
- Hawksworth, D.L.; Lücking, R. Fungal diversity revisited: 2.2 to 3.8 million species. Microbiol. Spectr. 2017, 5. [Google Scholar] [CrossRef] [PubMed]
- Wu, B.; Hussain, M.; Zhang, W.; Stadler, M.; Liu, X.; Xiang, M. Current insights into fungal species diversity and perspective on naming the environmental DNA sequences of fungi. Mycology 2019, 10, 127–140. [Google Scholar] [CrossRef]
- Kirchman, D.L. Genomes and meta-omics for microbes. In Processes in Microbial Ecology; Oxford University Press (OUP): Oxford, UK, 2018; Volume 1, pp. 73–91. [Google Scholar]
- Hyde, K.D.; Xu, J.; Rapior, S.; Jeewon, R.; Lumyong, S.; Niego, A.G.T.; Abeywickrama, P.D.; Aluthmuhandiram, J.V.S.; Brahamanage, R.S.; Brooks, S.; et al. The amazing potential of fungi: 50 ways we can exploit fungi industrially. Fungal Divers. 2019, 97, 1–136. [Google Scholar] [CrossRef]
- Selbmann, L.; Isola, D.; Fenice, M.; Zucconi, L.; Sterflinger, K.; Onofri, S. Potential extinction of Antarctic endemic fungal species as a consequence of global warming. Sci. Total. Environ. 2012, 438, 127–134. [Google Scholar] [CrossRef]
- Dobrzyńska, E.; Szewczynska, M.; Pośniak, M.; Szczotka, A.; Puchałka, B.; Woodburn, J. Exhaust emissions from diesel engines fueled by different blends with the addition of nanomodifiers and hydrotreated vegetable oil HVO. Environ. Pollut. 2019, 259, 113772. [Google Scholar] [CrossRef]
- Directive 2009/30/EC of the European Parliament and of the Council of 23 April 2009 Amending Directive 98/70/EC as Regards the Specification of Petrol, Diesel and Gas-Oil and Introducing a Mechanism to Monitor and Reduce Greenhouse Gas Emissions and Amending Council Directive 1999/32/EC as Regards the Specification of Fuel Used by Inland Waterway Vessels and Repealing Directive 93/12/EEC (Text with EEA relevance)—Document 32009L0030. Available online: https://eur-lex.europa.eu/legal-content/EN/TXT/?uri=celex%3A32009L0030 (accessed on 16 July 2021).
- Tesei, D.; Marzban, G.; Zakharova, K.; Isola, D.; Selbmann, L.; Sterflinger, K. Alteration of protein patterns in black rock inhabiting fungi as a response to different temperatures. Fungal Biol. 2012, 116, 932–940. [Google Scholar] [CrossRef]
- Schwarz, A.; Adetutu, E.M.; Juhasz, A.L.; Aburto-Medina, A.; Ball, A.S.; Shahsavari, E. Response of the fungal community to chronic petrogenic contamination in surface and subsurface soils. Geoderma 2018, 338, 206–215. [Google Scholar] [CrossRef]
- Teixeira, M.M.; Moreno, L.F.; Stielow, B.; Muszewska, A.; Hainaut, M.; Gonzaga, L.; Abouelleil, A.; Patané, J.S.L.; Priest, M.; Souza, R.; et al. Exploring the genomic diversity of black yeasts and relatives (Chaetothyriales, Ascomycota). Stud. Mycol. 2017, 86, 1–28. [Google Scholar] [CrossRef] [PubMed]
- Nascimento, M.M.; Vicente, V.A.; Bittencourt, J.V.; Gelinski, J.M.L.; Prenafeta-Boldú, F.X.; Romero-Güiza, M.; Fornari, G.; Gomes, R.R.; Santos, G.D.; Gerrits van den Ende, A.H.G.; et al. Diversity of opportunistic black fungi on babassu coconut shells, a rich source of esters and hydrocarbons. Fungal Biol. 2017, 121, 488–500. [Google Scholar] [CrossRef] [PubMed]
- Domsch, K.H.; Gams, W.; Anderson, T.H. Compendium of Soil Fungi, 2nd ed.; Academic Press: London, UK, 1980. [Google Scholar]
- Chen, W.-T.; Tu, M.-E.; Sun, P.-L. Superficial phaeohyphomycosis caused by Aureobasidium melanogenum mimicking tinea nigra in an immunocompetent patient and review of published reports. Mycopathologia 2016, 181, 555–560. [Google Scholar] [CrossRef] [PubMed]
- Van Nieuwenhuijzen, E.J.; Houbraken, J.A.M.P.; Meijer, M.; Adan, O.C.G.; Samson, R.A. Aureobasidium melanogenum: A native of dark biofinishes on oil treated wood. Antonie van Leeuwenhoek 2016, 109, 661–683. [Google Scholar] [CrossRef] [PubMed]
- Gostinčar, C.; Ohm, R.A.; Kogej, T.; Sonjak, S.; Turk, M.; Zajc, J.; Zalar, P.; Grube, M.; Sun, H.; Han, J.; et al. Genome sequencing of four Aureobasidium pullulans varieties: Biotechnological potential, stress tolerance, and description of new species. BMC Genom. 2014, 15, 549. [Google Scholar] [CrossRef] [PubMed]
- Chau, H.; Si, B.C.; Goh, Y.K.; Vujanovic, V. A novel method for identifying hydrophobicity on fungal surfaces. Mycol. Res. 2009, 113, 1046–1052. [Google Scholar] [CrossRef] [PubMed]
- Webb, J.; Van der Mei, H.C.; Nixon, M.; Eastwood, I.M.; Greenhalgh, M.; Read, S.J.; Robson, G.D.; Handley, P.S. Plasticizers increase adhesion of the deteriogenic fungus Aureobasidium pullulans to polyvinyl chloride. Appl. Environ. Microbiol. 1999, 65, 3575–3581. [Google Scholar] [CrossRef]
- Réblová, M.; Untereiner, W.A.; Réblová, K. Novel evolutionary lineages revealed in the Chaetothyriales (Fungi) based on multigene phylogenetic analyses and comparison of ITS secondary structure. PLoS ONE 2013, 8, e63547. [Google Scholar] [CrossRef]
- Gümral, R.; Tümgör, A.; Saraçli, M.A.; Yildiran, S.T.; Ilkit, M.; de Hoog, G.S.; Saraçlı, M.A.; Yıldıran, Ş.T. Black yeast diversity on creosoted railway sleepers changes with ambient climatic conditions. Microb. Ecol. 2014, 68, 699–707. [Google Scholar] [CrossRef]
- Bates, S.T.; Reddy, G.S.N.; Garcia-Pichel, F. Exophiala crusticola anam. nov. (affinity Herpotrichiellaceae), a novel black yeast from biological soil crusts in the Western United States. Int. J. Syst. Evol. Microbiol. 2006, 56, 2697–2702. [Google Scholar] [CrossRef] [PubMed][Green Version]
- Samerpitak, K.; Duarte, A.P.M.; Attili-Angelis, D.; Pagnocca, F.C.; Heinrichs, G.; Rijs, A.J.M.M.; Alfjorden, A.; Gerrits van den Ende, A.H.G.; Menken, S.B.J.; de Hoog, G.S. A new species of the oligotrophic genus Ochroconis (Sympoventuriaceae). Mycol. Prog. 2015, 14, 1–10. [Google Scholar] [CrossRef]
- Madrid, H.; Hernández-Restrepo, M.; Gené, J.; Cano, J.; Guarro, J.; Silva, V. New and interesting chaetothyrialean fungi from Spain. Mycol. Prog. 2016, 15, 1179–1201. [Google Scholar] [CrossRef]
- Cheewangkoon, R.; Groenewald, J.Z.; Hyde, K.D.; To-Anun, C.; Crous, P.W. Chocolate spot disease of Eucalyptus. Mycol. Prog. 2010, 11, 61–69. [Google Scholar] [CrossRef]
- Selbmann, L.; Zucconi, L.; Isola, D.; Onofri, S. Rock black fungi: Excellence in the extremes, from the Antarctic to space. Curr. Genet. 2014, 61, 335–345. [Google Scholar] [CrossRef] [PubMed]
- Schiaparelli, S.; Selbmann, L.; Onofri, S.; Zucconi, L.; Isola, D.; Rottigni, M.; Ghiglione, C.; Piazza, P.; Alvaro, M.C. Distributional records of Antarctic fungi based on strains preserved in the Culture Collection of Fungi from Extreme Environments (CCFEE) Mycological Section associated with the Italian National Antarctic Museum (MNA). MycoKeys 2015, 10, 57–71. [Google Scholar] [CrossRef]
- Quan, Y.; Muggia, L.; Moreno, L.F.; Wang, M.; Al-Hatmi, A.M.S.; Menezes, N.D.S.; Shi, D.; Deng, S.; Ahmed, S.; Hyde, K.D.; et al. A re-evaluation of the Chaetothyriales using criteria of comparative biology. Fungal Divers. 2020, 103, 47–85. [Google Scholar] [CrossRef]
- Isola, D.; Zucconi, L.; Onofri, S.; Caneva, G.; de Hoog, G.S.; Selbmann, L. Extremotolerant rock inhabiting black fungi from Italian monumental sites. Fungal Divers. 2016, 76, 75–96. [Google Scholar] [CrossRef]
- Isola, D.; Selbmann, L.; Meloni, P.; Maracci, E.; Onofri, S.; Zucconi, L. Detrimental rock black fungi and biocides: A study on the monumental cemetery of Cagliari. In Science and Technology for the Conservation of Cultural Heritage; Rogerio-Candelera, M.A., Lazzari, M., Cano, E., Eds.; CRC Press: London, UK, 2013; pp. 83–86. [Google Scholar]
- González-López, M.A.; Salesa, R.; González-Vela, M.C.; Fernández-Llaca, H.; Val-Bernal, J.F.; Cano-Lira, J.F. Subcutaneous phaeohyphomycosis caused by Exophiala oligosperma in a renal transplant recipient. Br. J. Dermatol. 2007, 156, 762–764. [Google Scholar] [CrossRef]
- Venkateshwar, S.; Ambroise, M.M.; Asir, G.J.; Mudhigeti, N.; Ramdas, A.; Authy, K.; Shivaprakash, M.R.; Kanungo, R. A rare case report of subcutaneous phaeohyphomycotic cyst caused by Exophiala oligosperma in an immunocompetent host with literature review. Mycopathologia 2014, 178, 117–121. [Google Scholar] [CrossRef]
- Vicente, A.; Domellöf, F.P.; Byström, B. Exophiala phaeomuriformis keratitis in a subarctic climate region: A case report. Acta Ophthalmol. 2018, 96, 425–428. [Google Scholar] [CrossRef] [PubMed]
- Abdolrasouli, A.; Gibani, M.M.; de Groot, T.; Borman, A.M.; Hoffman, P.; Azadian, B.S.; Mughal, N.; Moore, L.S.; Johnson, E.M.; Meis, J.F. A pseudo-outbreak of Rhinocladiella similis in a bronchoscopy unit of a tertiary care teaching hospital in London, United Kingdom. Mycoses 2021, 64, 394–404. [Google Scholar] [CrossRef] [PubMed]
- Chowdhary, A.; Perfect, J.; de Hoog, G.S. Black molds and melanized yeasts pathogenic to humans. Cold Spring Harb. Perspect. Med. 2014, 5, a019570. [Google Scholar] [CrossRef] [PubMed]
- Zeng, J.S.; Sutton, D.A.; Fothergill, A.W.; Rinaldi, M.G.; Harrak, M.J.; de Hoog, G.S. Spectrum of clinically relevant Exophiala species in the United States. J. Clin. Microbiol. 2007, 45, 3713–3720. [Google Scholar] [CrossRef] [PubMed]
- Silva, W.C.; Gonçalves, S.S.; Santos, D.W.C.L.; Padovan, A.C.B.; Bizerra, F.C.; Melo, A.S.A. Species diversity, antifungal susceptibility and phenotypic and genotypic characterisation of Exophiala spp. infecting patients in different medical centres in Brazil. Mycoses 2017, 60, 328–337. [Google Scholar] [CrossRef] [PubMed]
- Espanhol, C.M.; Recuero, J.K.; Pagani, D.M.; Ribeiro, A.C.; Vettorato, G.; Duquia, R.P.; Luzzatto, L.; Scroferneker, M.L. Cutaneous phaeohyphomycosis caused by Exophiala xenobiotica: A case report. Med. Mycol. Case Rep. 2019, 27, 39–41. [Google Scholar] [CrossRef]
- Moreno, L.F.; Vicente, V.; de Hoog, G.S. Black yeasts in the omics era: Achievements and challenges. Med. Mycol. 2018, 56, S32–S41. [Google Scholar] [CrossRef]
- Sood, S.; Vaid, V.; Sharma, M.; Bhartiya, H. Cerebral phaeohyphomycosis by Exophiala dermatitidis. Indian J. Med. Microbiol. 2014, 32, 188–190. [Google Scholar] [CrossRef]

| Species | CCFEE Collection No | Origin | GenBank Accession No | |
|---|---|---|---|---|
| ITS | LSU | |||
| Aulographina pinorum | 6220, 6222, 6230 | DPD, Italy | MZ573423 | |
| Aureobasidium melanogenum group | 6141, 6145, 6146, 6226, 6234, 6235, 6213, 6216, 6227, 6236, 6407, 6244, 6245, 6246, 6403, 6408 | DCT, DPD, GPD, Italy | MZ573420, MZ573421, MZ573422 | |
| Cladophialophora sp. | 6390 | DCT, Italy | MZ573430 | MZ956973 |
| Cladosporium herbarum group | 6184, 6199, 6016, 6192, 6193, 6027, 6029, 6030, 6031, 6054, 6148, 6191, 6378 | DCT, DPD, GPD, Italy | MZ573425, MZ573426, MZ573427 | |
| Cladosporium cladosporioides group | 6197, 6225, 6018, 6231, 6183, 6218, 6412 | DCT, DPD, GPD, Italy | MZ573428, MZ573429 | |
| Coniosporium cft. uncinatum | 6149 | GPD, Italy | MZ573424 | |
| Cyphellophora reptans | 6373, 6007, 6413, 6379, 6398 | DCT, DPD, GPD, Italy | MZ573432, MZ573434, MZ573433 | |
| Cyphellophora sp. | 6028 | DPD, Italy | MZ573431 | MZ956974 |
| Exophiala bonariae | 6041 | DPD, Italy | MZ573435 | |
| Exophiala crusticola | 6039, 6051, 6058, 6004, 6005, 6006, 6010, 6014, 6015, 6019, 6020, 6022, 6023, 6024, 6025, 6026, 6178, 6188, 6224, 6232 | DCT, DPD, GPD, Italy | MZ573436, MZ573437, MZ573438 | |
| Exophiala heteromorpha | 6150, 6181, 6339, 6343, 6240, 6241, 6243 | DCT, DPD, GPD, Italy | MZ573439, MZ573440 | |
| Exophiala oligosperma | 6139, 6345, 6360 | DCT, Italy | MZ573441 | |
| Exophiala xenobiotica | 6140, 6142, 6143, 6179, 6180, 6185, 6186, 6187, 6190, 6196, 6219, 6223, 6229, 6333, 6335, 6340, 6341, 6342, 6344, 6346, 6351, 6352, 6353, 6362, 6364, 6365, 6367, 6368, 6369, 6371, 6372, 6374, 6375, 6376, 6381, 6382, 6383, 6384, 6385, 6386, 6389, 6393, 6394, 6395, 6396, 6397, 6399, 6404, 6157, 6189, 6194, 6195, 6221, 6233, 6237, 6336, 6337, 6338, 6377, 6410, 6008, 6182, 6217, 6228, 6238, 6239, 6350, 6354, 6355, 6356, 6357, 6400, 6405, 6406 | DCT, DPD, GPD, Italy | MZ573442, MZ573443, MZ573444 | |
| Exophiala phaeomuriformis | 6242, 6358, 6359 | DCT, DPD, Italy | MZ573445, MZ573446 | |
| Exophiala sp. 1 | 6135 | DPD, Italy | MZ573447 | OK178849 |
| Exophiala sp. 2 | 6334, 6402 | DCT, Italy | MZ573448 | MZ956975 |
| Exophiala sp. 3 | 6348 | GPD, Italy | MZ573449 | MZ956976 |
| Exophiala sp. 4 | 6370 | DCT, Italy | MZ573450 | MZ956977 |
| Exophiala sp. 5 | 6387 | DCT, Italy | MZ573451 | MZ956978 |
| Extremus cft antarcticus | 6349 | DCT, Italy | MZ573453 | |
| Herpotrichiellaceae sp. | 6392 | DCT, Italy | MZ573459 | MZ956980 |
| Knufia epidermidis | 6138, 6198, 6366 | DCT, Italy | MZ573455 | |
| Knufia tsunedae | 6411 | GPD, Italy | MZ573456 | |
| Knufia sp. | 6034 | DPD, Italy | MZ573457 | MZ956979 |
| Lithohypha sp. | 6069 | GPD, Italy | MZ573458 | OK178850 |
| Neodevriesia sp. | 6136 | GPD, Italy | MZ573461 | OK178852 |
| Rhinocladiella similis | 6361 | DCT, Italy | MZ573467 | |
| Scolecobasidium sp. 1 | 6154, 6155, 6156, 6152, 6153, 6318 | DCT, GPD, Italy | MZ573462, MZ573463 | MZ956981 |
| Scolecobasidium sp. 2 | 6363 | DCT, Italy | MZ573464 | MZ956982 |
| Scolecobasidium sp. 3 | 6391 | DCT, Italy | MZ573465 | MZ956983 |
| Scolecobasidium sp. 4 | 6388 | DCT, Italy | MZ573466 | MZ956984 |
| Teratosphaeriaceae sp. | 6137 | GPD, Italy | MZ573460 | OK178851 |
| DCT | DPD | GPD | Total | |
|---|---|---|---|---|
| No. of isolates | 52 | 30 | 42 | 124 |
| No. of positive sampling sites | 25 | 21 | 29 | 75 |
| No. of taxa | 21 | 13 | 14 | 32 |
| Shannon index | 2.522 | 2.434 | 2.367 | 2.687 |
| Simpson index | 0.8145 | 0.8828 | 0.8722 | 0.8558 |
| Chao-1 index | 43.31 | 18.08 | 19.13 | 101.4 |
Publisher’s Note: MDPI stays neutral with regard to jurisdictional claims in published maps and institutional affiliations. |
© 2021 by the authors. Licensee MDPI, Basel, Switzerland. This article is an open access article distributed under the terms and conditions of the Creative Commons Attribution (CC BY) license (https://creativecommons.org/licenses/by/4.0/).
Share and Cite
Isola, D.; Scano, A.; Orrù, G.; Prenafeta-Boldú, F.X.; Zucconi, L. Hydrocarbon-Contaminated Sites: Is There Something More Than Exophiala xenobiotica? New Insights into Black Fungal Diversity Using the Long Cold Incubation Method. J. Fungi 2021, 7, 817. https://doi.org/10.3390/jof7100817
Isola D, Scano A, Orrù G, Prenafeta-Boldú FX, Zucconi L. Hydrocarbon-Contaminated Sites: Is There Something More Than Exophiala xenobiotica? New Insights into Black Fungal Diversity Using the Long Cold Incubation Method. Journal of Fungi. 2021; 7(10):817. https://doi.org/10.3390/jof7100817
Chicago/Turabian StyleIsola, Daniela, Alessandra Scano, Germano Orrù, Francesc Xavier Prenafeta-Boldú, and Laura Zucconi. 2021. "Hydrocarbon-Contaminated Sites: Is There Something More Than Exophiala xenobiotica? New Insights into Black Fungal Diversity Using the Long Cold Incubation Method" Journal of Fungi 7, no. 10: 817. https://doi.org/10.3390/jof7100817
APA StyleIsola, D., Scano, A., Orrù, G., Prenafeta-Boldú, F. X., & Zucconi, L. (2021). Hydrocarbon-Contaminated Sites: Is There Something More Than Exophiala xenobiotica? New Insights into Black Fungal Diversity Using the Long Cold Incubation Method. Journal of Fungi, 7(10), 817. https://doi.org/10.3390/jof7100817

